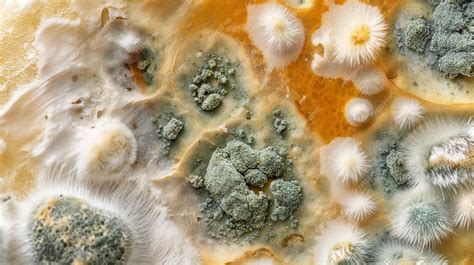
ejemplo de gráfico comparando el crecimiento del moho en diferentes temperaturas a lo largo de 10 días

El moho es un organismo que a menudo subestimamos, asociándolo principalmente con la descomposición de alimentos como el pan o el queso. Sin embargo, el moho es un organismo fascinante con una rica historia de usos y una influencia significativa en nuestra vida. Comprender su crecimiento y sus propiedades puede ser de gran interés científico e industrial.

Comprendiendo el Crecimiento del Moho
Es una observación común que la comida parece enmohecerse más rápido en verano que en invierno, y que los alimentos conservados en refrigeradores duran más que los expuestos al sol. Esto nos lleva a cuestionar si la temperatura realmente afecta la velocidad a la que crece el moho.
El Experimento del Pan con Moho
Este experimento está diseñado para demostrar la hipótesis de que "el moho crece más rápido a temperaturas más elevadas". Se trata de una investigación accesible que, en tan solo diez días, permite a los participantes hacer una contribución a la ciencia.
Aviso Importante de Seguridad
Es crucial tener en cuenta que algunas personas son alérgicas al moho. Si este es tu caso, no debes realizar el Experimento del Pan con Moho. Siempre se deben utilizar guantes y mascarilla, lavarse las manos meticulosamente y evitar comer o beber durante la realización del estudio.
Materiales Necesarios para el Experimento
- 15 rebanadas de pan (cualquier tipo es válido, se recomienda pan de molde blanco económico por su uniformidad). Es importante anotar la marca y fecha de caducidad para posibles réplicas.
- 15 bolsas herméticas para sándwich.
- 1 trozo de plástico transparente con un cuadro de 10x10 cm dibujado.
- Hisopo.
- Cuchillo limpio.
- Tabla de cortar.
- Etiquetas adhesivas.
- Marcador.
- Esporas de moho (si no se consiguen en la escuela, las esporas presentes en el aire permitirán el crecimiento, aunque el experimento tardará más).
- Mascarilla.
- Guantes.
Método de Realización del Experimento
- Marca las bolsas con etiquetas adhesivas y marcador: 5 bolsas como "A", 5 como "B" y 5 como "C". Identifica cada conjunto de bolsas con números del 1 al 5.
- Corta el pan en cuadrados de 10x10 cm utilizando la tabla de cortar y el cuchillo.
- Inocula el pan completamente con la solución de moho, procurando aplicar una cantidad similar de cultivo en cada rebanada, aunque esto pueda ser difícil.
- Coloca una rebanada de pan inoculado en cada bolsa y séllalas herméticamente.
- Guarda las 5 bolsas "A" en el congelador, las 5 bolsas "B" en el refrigerador y las 5 bolsas "C" en un lugar cálido y seguro. Para asegurar que la luz sea una constante, cubre las bolsas "C" si las del congelador y refrigerador reciben poca luz.
- Cada 24 horas, preferiblemente a la misma hora, utiliza la rejilla de plástico para contar los centímetros cuadrados de moho en cada rebanada. Si el moho cubre más de la mitad de un cuadrado, cuéntalo como 1 cm²; si es menos de la mitad, cuéntalo como 0 cm². Nunca abras las bolsas.
- Repite estos conteos durante 10 días o hasta obtener resultados medibles significativos.
- Anota cuidadosamente los resultados de cada rebanada de pan. Se recomienda tomar fotos o dibujar las rebanadas para un registro más científico.
- Promedia los resultados de los tipos de muestras A, B y C.
- Una vez finalizado el experimento, desecha todas las bolsas sin abrirlas.

Análisis de Resultados
Dado que cada cuadrado de pan mide 100 cm², los resultados pueden expresarse en forma de porcentaje. Para cada tipo de pan (A, B y C), promedia la cantidad de moho crecido a lo largo de los diez días y anota estos datos en una tabla. Posteriormente, esta información puede ser representada en un gráfico, comparando la cantidad de moho con el número de días. Esto se puede realizar utilizando papel cuadriculado y lápices de colores o mediante una computadora.
Importancia de los Resultados
La industria alimentaria invierte millones de dólares anualmente en refrigeración, y comprender la temperatura óptima para detener el crecimiento del moho es fundamental. Los alimentos mohosos deben ser desechados, lo que genera costos significativos para restaurantes y productores. Por otro lado, las empresas que utilizan moho para la producción de alimentos o medicamentos necesitan conocer las condiciones de temperatura que favorecen su crecimiento para optimizar sus procesos y la venta de sus productos.
Explorando Más Variables: Otros Experimentos con Moho
Una vez completado el experimento principal, se pueden explorar otras variables que afectan la velocidad de crecimiento del moho. Por ejemplo, se podría mantener la misma temperatura para todas las muestras pero utilizar diferentes tipos de pan, o añadir humedad, diferentes cantidades de azúcar o jugo de limón. La clave es cambiar una sola cosa a la vez para realizar estudios interesantes.
Datos Fascinantes sobre el Moho
El moho no es una planta, sino un hongo, similar a los champiñones o las setas. Crece en alimentos y otras materias orgánicas, descomponiéndolas y extrayendo nutrientes para su crecimiento.
El Moho y la Medicina
Alexander Fleming descubrió que un tipo común de moho era capaz de matar gérmenes, lo que lo llevó a desarrollar la penicilina, un medicamento que ha salvado millones de vidas. Numerosos otros medicamentos vitales también se derivan de químicos obtenidos del moho.
El Moho como Agente de Limpieza Natural
El moho desempeña un papel crucial como uno de los "limpiadores" de la naturaleza. Degrada la materia orgánica muerta y recicla nutrientes, devolviéndolos al suelo, lo que lo hace esencial en casi todos los ecosistemas del mundo.
Usos Culinarios del Moho
Utilizamos moho en la elaboración de ciertos alimentos para conferirles sabor y textura, como en el caso del queso azul, la salsa de soja y el Quorn®.
El Pan: Un Alimento Fundamental a Través de la Historia
El pan, derivado del latín "panis", es un alimento básico preparado generalmente mediante el horneado de una masa compuesta principalmente de cereal, agua y sal. El trigo es el cereal más utilizado, aunque también se emplean el centeno, la cebada, el maíz y el arroz.
Tipos de Pan y su Evolución
El pan elaborado sin levadura se conoce como pan ácimo y carece de la esponjosidad característica del pan levado. Las elaboraciones más primitivas de pan probablemente no incluían levadura, utilizando simplemente granos molidos mezclados con agua y secados al sol o entre las cenizas del fuego. El pan plano, popular en diversas culturas, es posiblemente la forma más antigua de pan.

Las galletas y los pasteles son variantes del pan con masas azucaradas. La masa del pan puede adoptar diversas formas mediante moldes y técnicas de amasado, dando lugar a hogazas, barras, bollos, chuscos, chapatas y pistolas, entre otros.
La Importancia Cultural y Nutricional del Pan
El pan ha sido tan fundamental en la alimentación humana que en muchas culturas se considera sinónimo de alimento. Actualmente, es uno de los alimentos básicos disponibles en la mayoría de tiendas y supermercados.
Pan en la Antigüedad
El pan fue el alimento básico de la humanidad desde la prehistoria. Se cree que los primeros bollos de pan se elaboraban con harinas de bellota o hayucos. Hallazgos arqueológicos en yacimientos cercanos a lagos suizos han revelado fragmentos de pan ácimo. Los egipcios ya elaboraban pan en la antigüedad, y de ellos datan las primeras evidencias del uso de levadura y hornos en su preparación. En la Antigua Roma, existían hornos públicos durante la República, y el pan era un alimento habitual para los legionarios romanos, quienes a menudo complementaban su dieta con aceitunas y pan.

La expansión del Imperio Romano llevó el consumo de pan a otras regiones, como Alemania y Suecia. Con la caída del Imperio, se produjo un desabastecimiento de trigo en Europa, que se había acostumbrado a su consumo masivo.
El Pan en la Edad Media y la Era Moderna
En la Edad Media, ante la escasez de trigo, comenzaron a elaborarse distintos tipos de pan y su comercio. El pan blanco era un lujo reservado para los ricos, mientras que el pan negro, hecho de cebada, centeno o avena, era para el resto de la población. La producción se realizaba artesanalmente en el hogar o en hornos públicos.
La ampliación del sistema alimentario introdujo cambios en los hábitos dietéticos, y el pan dejó de ser el único alimento básico para la mayoría de la población. La introducción de maquinaria en la elaboración del pan mejoró los procesos de molienda y horneado, transformándolo de un producto artesanal a uno industrial con la adición de diversos aditivos. Actualmente, la maquinaria facilita enormemente el trabajo, empleándose amasadoras, hornos automáticos, transportadoras, enfriadoras, cortadoras y máquinas envolvedoras.
Ingredientes Fundamentales del Pan
Los ingredientes básicos y necesarios para la elaboración del pan son la harina y el agua. La sal es un componente opcional que se añade para dar sabor y fortalecer la masa, aunque en algunas regiones, como en la Toscana, Italia, se elabora pan sin sal.
La Harina: Componente Esencial
La harina es el ingrediente principal del pan y se obtiene de la molienda fina de cereales hasta obtener una textura en polvo, generalmente del endosperma. La finura de la molienda varía según el uso final (pastas, panadería, repostería). Se comercializa en paquetes de aproximadamente un kilogramo, presentados en papel o cartón.
El Gluten y el Almidón
- Gluten: Conjunto de proteínas insolubles en agua (glutenina y gliadina) procedentes de los cereales molidos. Proporciona a la masa un aspecto compacto y elástico, similar al chicle. Es responsable de atrapar el dióxido de carbono liberado durante la fermentación, provocando el "hinchamiento" de la masa. En medio acuoso, las cadenas de aminoácidos se alinean formando redes proteicas que otorgan la textura final.
- Almidón: Representa aproximadamente el 70% del peso de la harina y proporciona la energía necesaria para el crecimiento futuro de la planta. Se presenta en forma de gránulos compuestos por amilosa y amilopectina. Los almidones distribuyen la humedad de forma homogénea durante el amasado y proporcionan una estructura semisólida a la masa.
El porcentaje de gluten define los tipos de harina: las harinas de fuerza tienen un alto contenido de gluten (superior al 11%), lo que requiere más esfuerzo al amasar debido a su resistencia al estirado. Las harinas débiles, con bajo contenido de gluten, son más fáciles de manipular. El trigo es rico en gluten, lo que permite crear una textura esponjosa, mientras que la cebada o la avena tienen menos gluten y menor capacidad de retener CO₂.
El Agua: Activador y Estabilizador
El agua activa las proteínas de la harina, otorgando a la masa una textura blanda y moldeable. Además, disuelve las sustancias añadidas y es necesaria para la fermentación. La composición química del agua y su proporción influyen en la calidad del pan. La cantidad de agua suele ser del 43% del volumen total de la masa (o 66.6% del peso de la harina). Un contenido acuoso inferior al 43% resulta en una masa menos extensible y más densa. La capacidad de absorción de agua de una harina depende del tipo de cereal y su contenido proteico.
Los panaderos utilizan la "tasa de hidratación" o "porcentaje de panadero", donde el peso de la harina es el 100% y el resto de los ingredientes se miden en proporción. El agua puede representar entre el 50% y el 70% del peso de la harina. Aguas con carácter ácido endurecen la red de gluten, mientras que las alcalinas la suavizan. Por ello, a veces se emplean aguas minerales o filtradas.
El proceso de hidratación de la masa tras su mezcla con agua puede durar entre diez y veinte minutos, un tiempo necesario para que la masa se impregne completamente.
La Sal: Potenciador de Sabor y Textura
La sal es un ingrediente opcional que refuerza los sabores y aromas del pan, y afecta su textura final (hasta un 2% del peso total de la harina). El pan tradicional a menudo no lleva sal, pero masas como los cruasanes o brioches la incorporan en mayores cantidades para equilibrar el sabor de la mantequilla. Se suelen emplear sales marinas poco refinadas. La sal contribuye indirectamente al color marrón de la corteza al retardar la fermentación, generando un exceso de azúcares que favorecen el dorado durante el horneado.
En algunos casos, se aconseja añadir la sal después de la fermentación completa para evitar inhibir las levaduras (proceso conocido como autólisis). Las autoridades sanitarias han establecido acuerdos para limitar el contenido de sal en el pan debido a su relación con la hipertensión arterial.
La Levadura: El Motor de la Fermentación
La levadura es un conjunto de microorganismos unicelulares (hongos) que se alimentan del almidón y azúcares de la harina. A través de la fermentación alcohólica, producen etanol y dióxido de carbono (CO₂). El gas liberado hincha la masa, y el alcohol se evapora durante el horneado.
Aunque se ha empleado desde hace miles de años, la comprensión científica de la fermentación como proceso biológico se consolidó con las investigaciones de Louis Pasteur. La clave de su uso es la generación de gas que infla la masa. El proceso de fermentación es altamente dependiente de la temperatura, alcanzando su máxima velocidad a 35°C.
Existen más de cien especies de levaduras; la Saccharomyces cerevisiae es la responsable de la fermentación del pan, el vino y la cerveza. Una molécula de glucosa se transforma en dos moléculas de etanol y dos de dióxido de carbono.
Tipos de Levadura
- Levadura seca: Obtenida de tanques de fermentación y deshidratada. Se reactiva en agua templada (25-30°C) antes de usarse. Las levaduras instantáneas no requieren prehidratación y se mezclan directamente con la harina y el agua, a menudo proporcionando CO₂ de forma más vigorosa.
- Levadura fresca: Obtenida inmediatamente de la fermentación y refrigerada en forma de cubos pastosos, con una vida útil corta.
- Levadura química: Compuestos químicos que generan gases (principalmente CO₂).
- Levaduras naturales: Presentes en el propio cereal, la atmósfera, etc.
La cantidad de levadura utilizada varía entre el 0.5-4% del peso de la harina (las levaduras secas se usan en la mitad de cantidad). A veces se emplean prefermentadores (poolish) o masa madre, que son cultivos de levaduras y bacterias (como Lactobacillus plantarum) que generan CO₂ y ácido láctico, mejorando el sabor y la textura del pan.